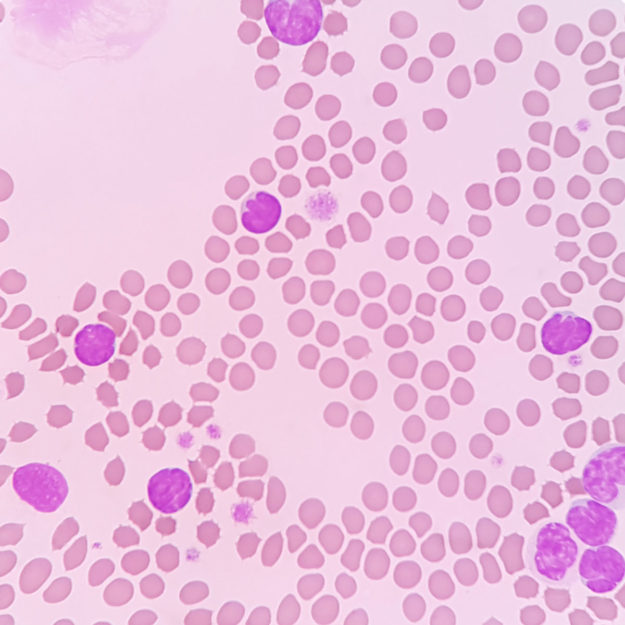

Join Mission Veterinary Partners and Dr. Aaron Caplan for a deep dive in Hypercalcemia in practice.
Misson Veterinary Partners and VetPrep are thrilled to join Dr. Aaron Caplan for an interactive case-based presentation focused on navigating hypercalcemia in practice! Let Dr. Caplan be your mentor and guide through a fun and challenging case as you work your way from signalment and presentational all the way to diagnosis, treatment, and everything between. Dr.…